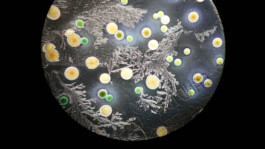

Micro Macro - Life Sciences in Jena
In Jena, seven research institutions have joined forces with cultural mediators to open up a very special cosmos to current and future science enthusiasts: the spectrum of life sciences in Jena.
A broad selection of unique projects from Jena's traditional as well as innovative research landscape is presented in the photos of the MicroMacro exhibition shown here. From bacteria and fungi to plants and insects to humans, visitors can dive into the world of microbes, discover the diversity in ecosystems, observe molecular processes in cells and watch how diseases develop, are diagnosed and cured. Often, science is perceived as something intangible, abstract. But in this exhibition the life sciences show that they offer excellent points of contact for our own perception, since they examine our immediate environment as well as human beings themselves.
In Jena, excellent and interdisciplinary research is being conducted following the slogan "LIGHT, LIFE, LIBERTY - Connecting Visions.". With the university as an anchor point and networking center, scientists from the university, non-university institutes, the university hospital and research-oriented companies work closely together. In the exhibition initiated by Dr. Franziska Eberl, one of the three research profile areas, the "LIFE" profile, is being introduced. It represents the life sciences, which include research topics embedded in biology, medicine, chemistry and geology. Fascinating images of the smallest biological structures, such as we can take nowadays with high-performance microscopes, would not have been possible without the collaboration of Carl Zeiss, Ernst Abbe and Otto Schott. Innovation and interdisciplinarity is part of the history of Jena´s scientific landscape. The modern current scientific landscape of young scientists is made visible in the exhibition "Micro Macro - Life Sciences in Jena".
Exhibits